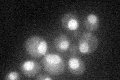
YHL020C
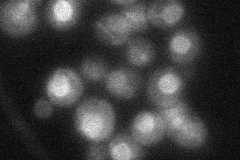
YHL020C
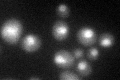
YHL020C

View description
Transcriptional regulator of a variety of genes; phosphorylation by protein kinase A stimulates Opi1p function in negative regulation of phospholipid biosynthetic genes; involved in telomere maintenance
Localization:
Intensity:
Fold change:
Significance:
-
C’ GFP library in SD
nucleus30.8 -
N' NOP1pr-GFP in SD

nuclear periphery43.1014 -
N' TEF2pr-mCherry in SD

punctate,nuclear periphery30.3899 -
N' NATIVEpr-GFP in SD
nuclear periphery25.1395 -
N' TEF2pr-VC and Cyto-VN in SD

below threshold27.4387 -
C’ GFP library in SD+DTT
nucleus26.820.87No -
C’ GFP library in SD+H2O2

nucleus33.421.08No -
C’ GFP library in Starvation Media

nucleus17.370.56Yes -
C’ GFP library on the background of Pup2-DaMP

N/A -
C’ GFP library on the background of CCT mutant

N/A0N/AYes
